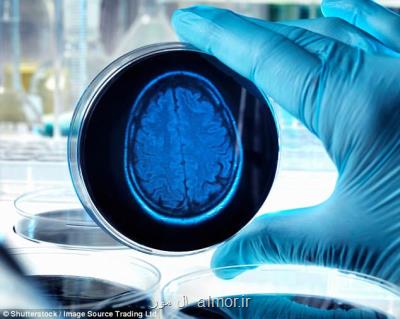
افزایش سرعت مبتلا شدن به زوال عقل در جهان

سازمان جهانی بهداشت هشدار داد
افزایش سرعت مبتلا شدن به زوال عقل در جهان
سازمان جهانی بهداشت (WHO) در گزارش جدیدی اخطار داد که آمار مبتلا شدن به دمانس (زوال عقل) به شکل هشداردهنده ای رو به فزونی است و تا سال ۲۰۳۰ میلادی شمار مبتلایان ۴۰ درصد بیشتر می شوند.
سازمان جهانی بهداشت (WHO) در گزارش جدیدی اخطار داد که آمار مبتلا شدن به دمانس (زوال عقل) به شکل هشداردهنده ای رو به فزونی است و تا سال ۲۰۳۰ میلادی شمار مبتلایان ۴۰ درصد بیشتر می شوند.
به گزارش ال مور به نقل از ایسنا، مطالعه سازمان جهانی بهداشت (WHO) نشان داده است که جمعیت دنیا در سالهای آتی با رشد سریع مبتلا شدن به زوال عقل روبرو خواهد بود و این تحقیق نتیجه گرفته است که تعداد بیماران درگیر دمانس در سال ۲۰۳۰ میلادی دستکم ۴۰ درصد بیش تر از میزان کنونی می شود.
مبنای این نتیجه گیری، پیرتر شدن هر چه بیشتر شهروندان و عدم آمادگی اغلب کشورها برای مواجهه با کهنسالی و پیامدها و عوارض این دوران عمر است.
بنابر اعلام سازمان ملل بیشتر از ۵۵ میلیون نفر در سرتاسر جهان با زوال عقل زندگی می کنند.
تدروس آدهانوم، دبیرکل سازمان جهانی بهداشت گفته است که باید برای نگهداری، مراقبت و پشتیبانی از افراد مبتلا به دمانس مجهز بود و آنها و اطرافیان شان را به حال خود رها نکرد.
وی با تمجید از استراتژی دولت آلمان برای پشتیبانی و پرستاری از مبتلایان به این عارضه تاکید کرده است: هدف همه کشورها باید این باشد که منزلت سالخوردگان مبتلا به زوال عقل حفظ شود و آنها به حاشیه اجتماع رانده نشوند.
همینطور یک کارشناس سازمان جهانی بهداشت در زمان عرضه نتایج پژوهش این نهاد خاطرنشان کرد که رعایت مجموعه ای از ساز و کارها می تواند نرخ مبتلا شدن به دمانس را به طرز قابل توجهی کم کند. سبک زندگی سالم، ارتباطات اجتماعی خلاق، تعاملات عاطفی و آموزش و سواد مناسب، در جلوگیری از ابتلای سالخوردگان به زوال عقل تأثیر قاطع دارند.
به گزارش دویچه وله، دمانس یا زوال عقل با اختلال در حافظه، تغییرات رفتاری و شخصیتی، روان پریشی یا زبان پریشی همراه می باشد. کهنسالان مبتلا، خلق و خوی ناپایدار دارند. آنها به تناوب گرفتار افسردگی و اضطراب، توهم و خیالات و هذیان می شوند. برخی بدون عامل محرک بیرونی، گاه به شدت می خندند یا گریه می کنند و گروهی هم مهارت های کلامی و زبانی را از دست می دهند و در بیان مقصود، وا می مانند.
دمانس می تواند در اثر عوامل مختلفی همچون اختلالات تیروئید، کمبود ویتامین، عوارض جانبی داروها، افسردگی، اضطراب، عفونت ها، سکته های مغزی، پارکینسون و سایر مشکلات پزشکی و سلامتی ایجاد شود. این اختلال عمدتا با آلزایمر یکسان گرفته می شود در حالیکه آلزایمر زیر مجموعه ای از این سندرم است. بین۶۰ تا۸۰ درصد از کل تشخیص های دمانس به آلزایمر (فراموشی یا نسیان) ختم می شود.
منبع: ال مور
این مطلب را می پسندید؟
(0)
(0)
تازه ترین مطالب مرتبط
نظرات کاربران عزیز ال مور در مورد این پست
نظر شما در مورد این مطلب ال مور
نام:
ایمیل:
نظر شما:
سوال:
= ۴ بعلاوه ۱